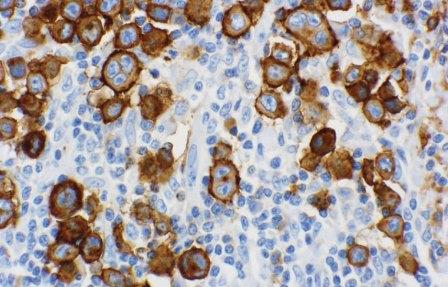
Just released: The September issue of Archives of Pathology &amp; Laboratory Medicine is now available:

Visabl.com
@visabl_dot_com
Visabl.com is an antibody search engine for researchers, pathologists, and technologists looking for new IVD Immunohistochemical markers
ID: 2336072190
http://www.visabl.com 10-02-2014 04:20:15
845 Tweet
212 Followers
483 Following







Multiple system atrophy is first new human prion disease identified in 50 years. Genetic Engineering & Biotechnology News: ow.ly/RE0IJ






Read The histopathology Daily ▸ today's top stories via gmcrotty Bio-Rad Life Science Richard Jones paper.li/histopathology…